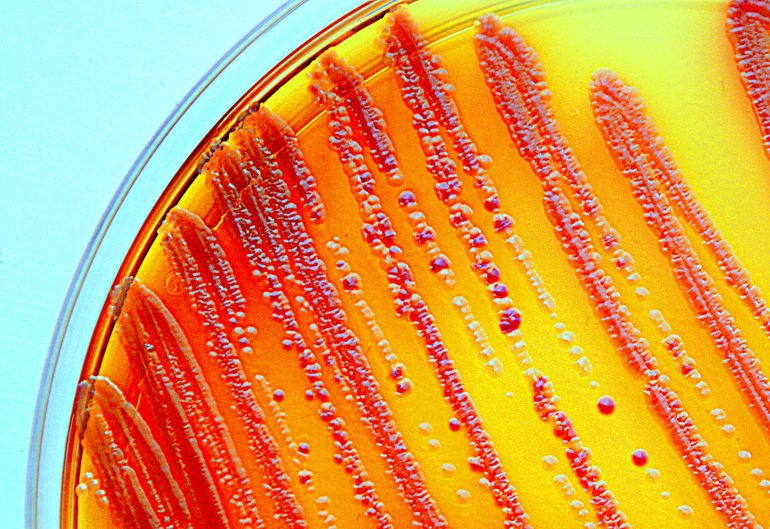
antibiotic resistant bacteria

One of the biggest battles in science is taking place at the microscopic level as we race to find something to combat the rising numbers of antibiotic resistant bacteria.
A team from the University of Melbourne is finding a novel solution to the rise of antibiotic resistant bacteria by developing nanoparticles to defeat drug-resistance.
How big is the problem?
Not to put too fine a point on it, but it’s a big concern, and we’re running out of time to find a solution.
Approximately 700,000 deaths each year are attributable to antibiotic resistant bacteria and resulting health issues; between now and 2050, that number is projected to rise to 10 million, according to the 2017 Review on Antimicrobial Resistance. The World Health Organisation names antibiotic resistant bacteria as one of the biggest threats to global health, food and development.
While bacteria are capable of developing resistance on their own thanks to rapid mutations and quick reproduction cycles, they are helped along by human behaviours including overuse or misuse of antibiotics and poor hygiene practices.
Small-sized solution
University of Melbourne Associate Professor Andrea O’Connor, deputy head of the School of Chemical and Biomedical Engineering, is applying her experiences in biomaterials, implants and tissue engineering to tackle this problem.
O’Connor began working with tissues, and the scaffolds or sponges implanted to encourage new tissue growth, almost two decades ago.
“Eventually, that material that we implanted would degrade away, but if that takes months or even up to a year, there’s risk of infection forming on that device,” she said in Pursuit.
She began investigating antimicrobial nanomaterials, which impede the growth of bacteria through a physical, rather than a chemical, means. The team collaborated with Dr Phong Tran from the University of Queensland, who specialises in nanotechnology.
“He has a background working with nanoparticles, and so that expertise boosted our interest and activity in this area,” O’Connor said.
The team looked at nanoparticles that could disrupt the cellular membrane around the bacteria. One mineral that did this particularly well was selenium, which humans need to boost immunity and metabolism. Selenium also has an advantage over another nanoparticle commonly used for medical purposes: silver, which has antimicrobial properties but can be toxic. They published these findings recently in the Journal of Colloid and Interface Science.
“One of the ways these [selenium] nanoparticles can attack bacteria is by disrupting the membrane so they make the bacteria leaky, and then things can pass in and out of the bacteria in a way they normally wouldn’t,” O’Connor said.
To further test the nanoparticles, the researchers incorporated them as a coating on the surface of a medical implant and tissue engineering scaffold. So far the selenium nanoparticles have successfully fended off attacks from nine different types of bacteria.
The fight continues
It’s unclear yet whether this method is a permanent solution to antibiotic resistant bacteria, but O’Connor is confident it can certainly help fill the gap as the efficacy of antibiotics continues to decline.
“The benefit of the nanoparticles that we’ve developed is they attack bacteria in multiple ways. It’s going to be difficult for the bacteria to develop resistance to all those different forms of attack,” she said
She has started to explore ways to use the material for treating chronic wounds like those found on patients with diabetes, as well as branching out into other industries.
“We’re interested in potential applications in the food industry, so we’re developing materials to help limit food spoilage and the risk of food-borne infections,” she said.